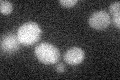
YOL122C
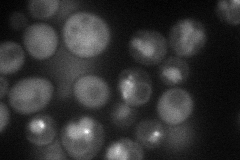
YOL122C
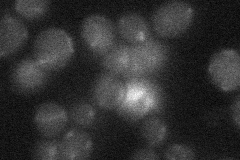
YOL122C

View description
Divalent metal ion transporter with a broad specificity for di-valent and tri-valent metals; post-translationally regulated by levels of metal ions; member of the Nramp family of metal transport proteins
Localization:
Intensity:
Fold change:
Significance:
-
C’ GFP library in SD
below threshold16.07 -
N' NOP1pr-GFP in SD
vacuole57.0284 -
N' TEF2pr-mCherry in SD

cytosol60.8166 -
N' NATIVEpr-GFP in SD
below threshold18.2649 -
N' TEF2pr-VC and Cyto-VN in SD

below threshold26.1753 -
C’ GFP library in SD+DTT

cytosol14.310.89No -
C’ GFP library in SD+H2O2

cytosol15.770.98No -
C’ GFP library in Starvation Media

cytosol15.040.93No -
C’ GFP library on the background of Pup2-DaMP

below threshold -
C’ GFP library on the background of CCT mutant

below threshold14.09280.876657No
